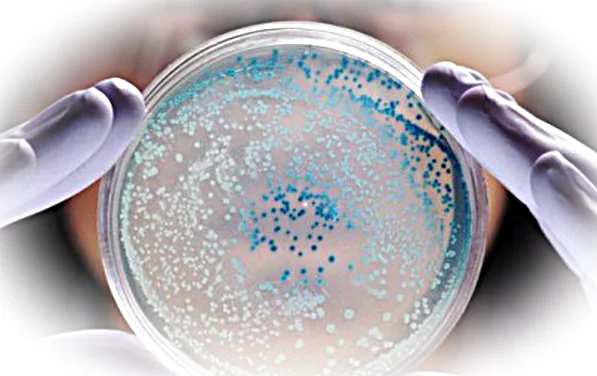

Уреаплазмоз – воспалительный процесс в мочеполовой системе человека, вызванный бактериями семейства уреаплазм. Чаще всего встречается уреаплазма у женщин, реже – у детей и мужчин. В большинстве случаев инфицированный человек может и не знать о наличии заболевания, которое протекает бессимптомно.
У женщин уреаплазмоз ведет к поражению мочевого пузыря и воспалению органов репродуктивной системы, развитию цистита, вагинита, эндометрита, мочекаменной болезни. Уреаплазма при беременности может привести к преждевременным родам, осложнению самого процесса родов, самопроизвольным выкидышам, инфицированию плода и новорожденного.
Виды бактерий уреаплазмы и их влияние на течение заболевания
Существует две клинически значимых бактерии, вызывающих заболевание уреаплазмоз:
1) уреаплазма уреалитикум (urealyticum) – является главным возбудителем уреаплазмоза, активная бактерия, вызывающая воспаление мочеполовых органов;
2) уреаплазма парвум (parvum) – «спящая» хроническая бактерия, которая живет в организме и проявляет себя в очень редких случаях, из-за препятствия иммунитета человека ее размножению и активности.
Оба вида объединяются в общее название уреаплазма spp (species). На фоне сниженного иммунитета, в период ослабленности организма другим заболеванием, беременности, происходит возбуждение уреаплазмы уреалитикум. Она также может активизироваться при появлении вторичной инфекции половых органов, например, хламидий, гонококков и т.д.
Не во всех случаях носителям уреаплазмы парвум лечение клинически показано, так как этот микроорганизм может находиться в организме всю жизнь и ни разу не проявить себя. Более того, при необходимости сдачи анализов женщинам до беременности, лабораторные исследования не всегда способны ее распознать.
Причины и симптомы уреаплазмы у женщин
Основной путь заражения – половой контакт с носителем инфекции. Вторая возможная причина – передача от матери к ребенку. Это может происходить, когда женщина имеет уреаплазму во время беременности и ребенок инфицируется, проходя через родовые пути.
Симптомы уреаплазмоза:
- резь и жжение при мочеиспускании;
- небольшие слизистые выделения;
- боли в области матки при ее воспалении.
Диагностика инфекции
Специалисты проводят полную диагностику уреаплазмы у женщин. Врач может назначить как один метод лабораторного исследования, так и несколько, для представления полной клинической картины заболевания:
- Бактериологический метод позволяет обнаружить бактерию путем посева, а также распознать антибиотик, к которому она чувствительна.
- Метод ПЦР на 100% определяет ее наличие или отсутствие в организме, а также позволяет разделить уреаплазму специес. При активной форме заболевания, это не конечный этап исследования, так как метод ПЦР не позволяет высчитать количество бактерий.
- Методы микроскопии ПИФ и ИФА тоже нередко используются, но как начальный быстрый этап исследования, который не может дать полной характеристики исследуемой инфекции.
- Серологический метод — исследование крови из вены на наличие антител чаще всего проводится для выявления уреаплазмы во время беременности.
Лечение уреаплазмы у женщин
Лечение проводится только после глубокой диагностики, которая определит степень опасности уреаплазмы спесиес и подтвердит повышенное ее количество. А уреаплазмы уреалитикум настолько устойчивы к некоторым медикаментам, что порой чрезвычайно сложно найти лекарство против этой инфекции.
В редких случаях лечение приводит к полному исчезновению инфекции, так как большинство антибиотиков имеют бактериостатическое действие, т.е. уменьшают количество бактерий, но не убивают их.

Для лечения уреаплазмы уреалитикум используются:
- антибиотики-макролиды: эритромицин, кларитромицин, азитромицин, флуритромицин, рокитамицин и др.;
- антибиотики тетрациклиного ряда: доксициклин и тетрациклин;
- фторхинолоны (в некоторых случаях): офлоксацин, ципрофлоксацин.
Многие перечисленные антибиотики не способны воздействовать на уреаплазму parvum, так она имеет к ним нулевую чувствительность. Для лечения этого вида инфекции или хронической формы уреаплазмоза, применяется продолжительная терапия специально подобранными комбинациями антибиотиков.
Лечение уреаплазмы при беременности, в основном, проводится в срок до 20-ти недель и перед родами. К примеру, уреаплазма парвум при беременности может не проявлять никаких симптомов, но способна передаться ребенку во время родов, поэтому лечение проводится в незадолго до рождения. Специалисты медицинского центра «Доктор Досталет» настоятельно рекомендуют проводить лечение уреаплазмы при беременности под строгим наблюдением врача, так как фторхинолоны и препараты на основе тетрациклина категорически запрещены в этот период. В основном применяются антибиотики-макролиды в строго дозированной форме и продолжительности курсов.
Профилактика уреаплазмоза
Во избежание обострения уреаплазмоза или его перехода в хроническую форму, а также для предохранения организма от инфекции, специалисты медицинского центра «Доктор Досталет» советуют для профилактики соблюдать некоторые правила:
- регулярно проходить профилактический осмотр у гинеколога;
- иметь половые контакты только с проверенными партнерами;
- избегать случайных половых связей;
- использовать презервативы, хотя они не всегда способны защитить от уреаплазмы spp.








